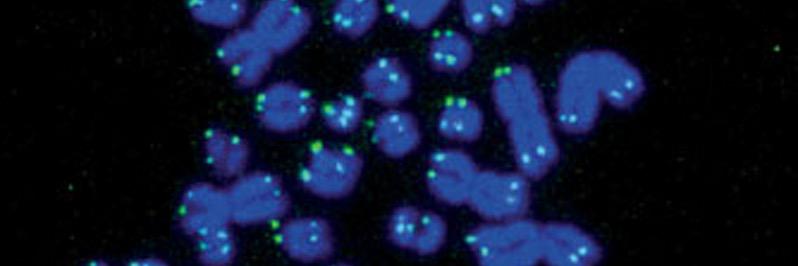
Dean H. Betts banner

Dean H. Betts
127 posts

Dean H. Betts
@Betts_Lab
The Betts Lab is currently examining the roles of the p66Shc adaptor protein and miRNAs in regulating stem cell function and early embryo development.














One of our PhD graduates!! Congrats Ian !!

#OVC welcomes an award-winning researcher Dr. Ian Tobias to the Department of Biomedical Sciences! @ITobiasLab specializes in bioinformatics + functional genomics to study untreatable neurological disorders. Full story: bit.ly/42brTdm @uofg @UofGuelphNews @UofGResearch


Science and research are fundamental building blocks of Canada that require sustained attention, nurture and support. Our world class researchers and students wait, while peer countries increase funding. Time to invest in the granting councils and graduate scholarships.






Underinvestment in health research is killing us. Read our open letter that was published in today’s edition of the @globeandmail to find out why and what can be done: ow.ly/Wyp150N7suu #ResearchIsTheSolution #CDNhealth #cdnpoli








